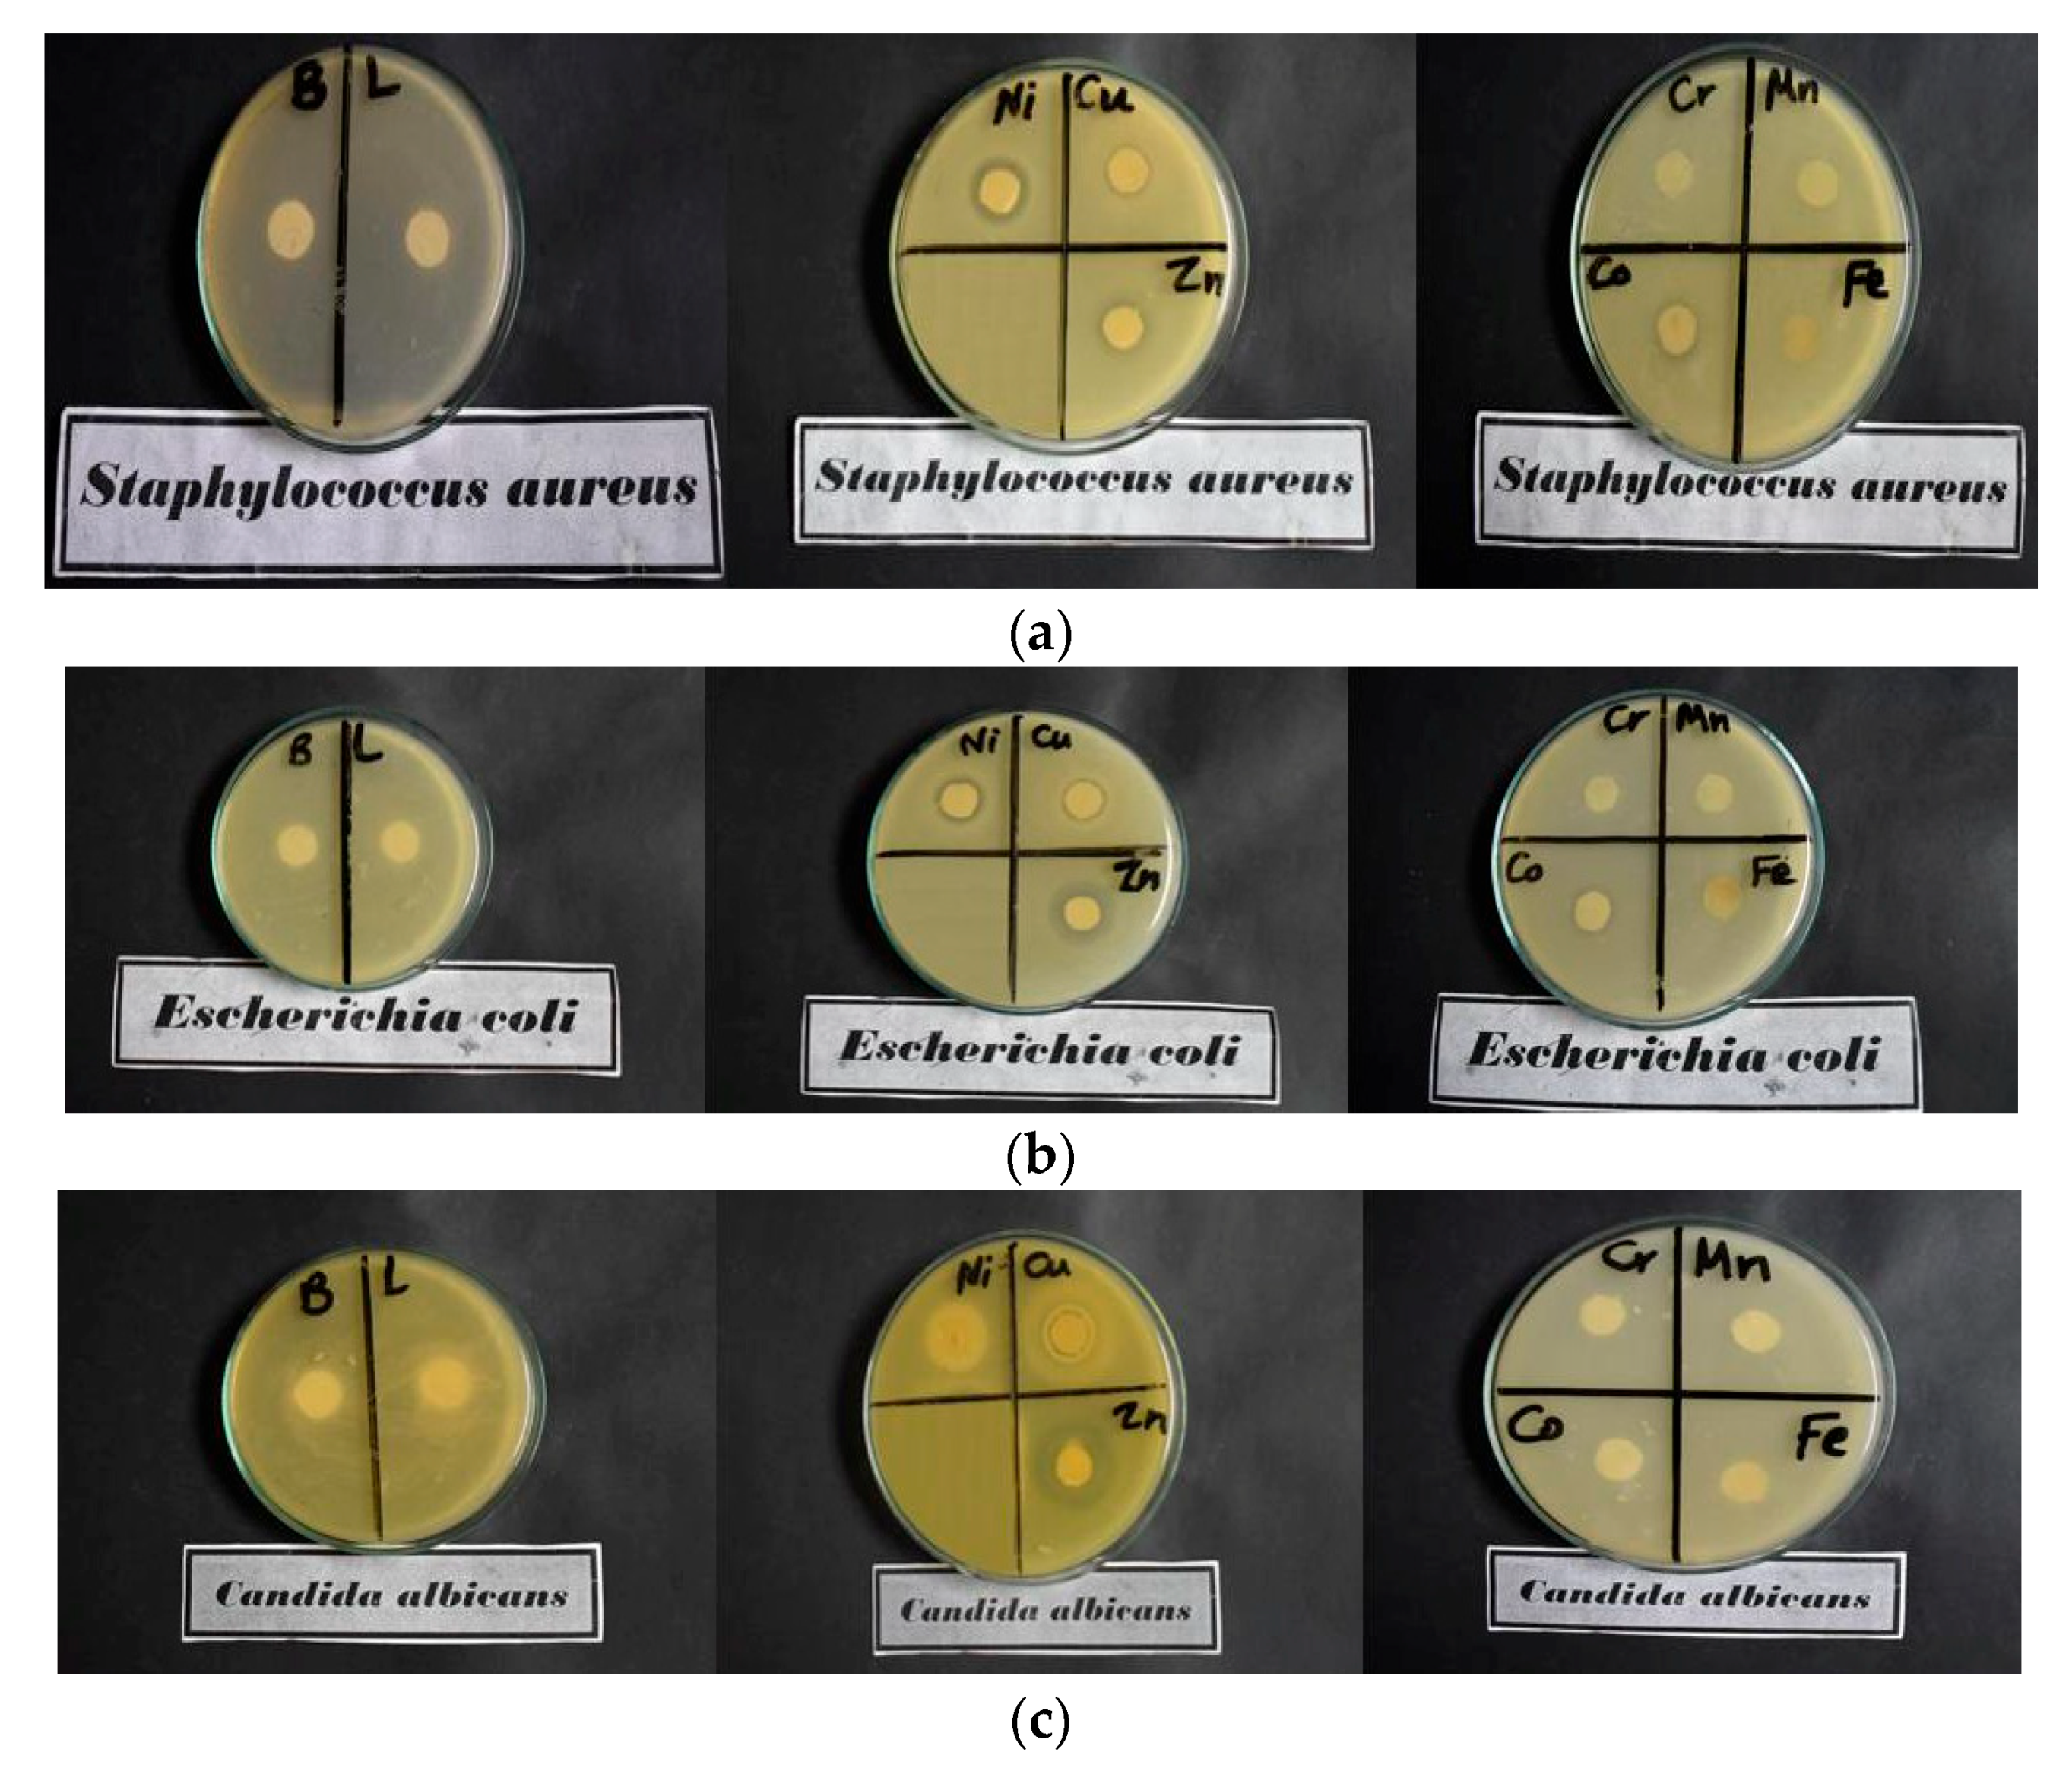
Materials 16 04885 g007a Materials 16 04885 g007a

Synthesis and Characterization of Pyridine Acetohydrazide Derivative for Antimicrobial Cotton Fabric
Abstract
1. Introduction
2. Materials and Methods
2.1. Materials
2.2. Chemicals
2.3. Syntheses of Acetohydrazide Ligand (AHZ)
2.4. Coating of Cotton Fabric (CF) with AHZ and M-AHZ
2.5. Instruments
2.6. Tensile Strength
2.7. The Add-On (%) Loading
2.8. Antimicrobial Efficiency
3. Results and Discussion
3.1. Characterizations of AHZ Ligand
3.1.1. NMR
3.1.2. FTIR Spectra of AHZ
3.2. Cotton Fabric Analysis
3.2.1. The Proposed Mechanism between CF and AHZ Derivative
3.2.2. FT-IR Spectra of the Modified Cotton
3.2.3. SEM/EDX Analysis
3.2.4. Antimicrobial Studies
3.2.5. The Add-On (%) and Tensile Strength
4. Conclusions
Author Contributions
Funding
Data Availability Statement
Acknowledgments
Conflicts of Interest
References
- Othman, I.M.; Gad-Elkareem, M.A.; Anouar, E.; Snoussi, M.; Aouadi, K.; Kadri, A. Novel fused pyridine derivatives containing pyrimidine moiety as prospective tyrosyl-tRNA synthetase inhibitors: Design, synthesis, pharmacokinetics and molecular docking studies. J. Mol. Struct. 2020, 1219, 128651. [Google Scholar] [CrossRef]
- Firdaus, A.; Tiwari, P.; Arfin, N. Effect of Glutraldehyde and Halloysite on Gelatin-Cellulose Gel: Application in Removal of Methylene Blue from Water. Carbohydr. Polym. Technol. Appl. 2022, 4, 100233. [Google Scholar] [CrossRef]
- Abd El-Hady, M.M.; Farouk, A.; Sharaf, S. Multiwalled-Carbon-Nanotubes (MWCNTs)–GPTMS/Tannic-Acid-Nanocomposite-Coated Cotton Fabric for Sustainable Antibacterial Properties and Electrical Conductivity. Coatings 2022, 12, 178. [Google Scholar] [CrossRef]
- Wen, W.; Zhang, Z.; Jing, L.; Zhang, T. Synthesis of a Hein–Schiff base compound and its antibacterial activity on cotton fabrics. Cellulose 2020, 27, 7243–7254. [Google Scholar] [CrossRef]
- Abd El-Hady, M.M.; Farouk, A.; Saeed, S.E.; Zaghloul, S. Antibacterial and UV Protection Properties of Modified Cotton Fabric Using a Curcumin/TiO2 Nanocomposite for Medical Textile Applications. Polymers 2021, 13, 4027. [Google Scholar] [CrossRef] [PubMed]
- Sharaf, S.; Farouk, A.; Abd El-Hady, M.M. Novel conductive textile fabric based on polyaniline and CuO nanoparticles. Int. J. Pharmtech Res. 2016, 9, 461–472. [Google Scholar]
- Farouk, A.; Saeed, S.E.; Sharaf, S.; Abd El-Hady, M.M. Photocatalytic activity and antibacterial properties of linen fabric using reduced graphene oxide/silver nanocomposite. RSC Adv. 2020, 10, 41600–41611. [Google Scholar] [CrossRef] [PubMed]
- Wei, Z.; Xinlan, D.; Jinjie, Z. Properties of Cotton Fabric Modified with a Chitosan Quaternary Ammonium Salt Nanoparticle. Fibres Text. East. Eur. 2018, 26, 116–121. [Google Scholar]
- Rodrigues, M.A.; Marzano, I.M.; Ribeiro, G.H.; Colina-Vegas, L.; Pivatto, M.; Fontes, A.P.; Ribeiro, C.M.; Pavan, F.R.; de Almeida, K.J.; Batista, A.A.; et al. Platinum(II) complexes with carbazates and hydrazides: Synthesis, spectral characterization, computational modeling, and biological studies. Polyhedron 2015, 98, 146–153. [Google Scholar] [CrossRef]
- Devi, P.P.; Chipem, F.A.; Singh, C.B.; Lonibala, R.K. Complexation of 2-amino-3-(4-hydroxyphenyl)-N′-[(2-hydroxyphenyl) methylene] propane hydrazide with Mn(II), Co(II), Ni(II), Cu(II) and Zn(II) ions: Structural characterization, DFT, DNA binding and antimicrobial studies. J. Mol. Struct. 2019, 1176, 7–18. [Google Scholar] [CrossRef]
- El-Medani, S.; Makhlouf, A.; Moustafa, H.; Afifi, M.; Haukka, M.; Ramadan, R. Spectroscopic, crystal structural, theoretical and biological studies of phenylacetohydrazide Schiff base derivatives and their copper complexes. J. Mol. Struct. 2020, 1208, 127860. [Google Scholar] [CrossRef]
- Elewa, S.I.; Abdelhamid, A.O.; Hamed, A.A.; Mansour, E. Synthesis, characterization, antimicrobial activities, anticancer of some new pyridines from 2, 3-dihydro-2-oxo-4-phenyl-6-(thien-2-yl) pyridine-3-carbonitrile. Synth. Commun. 2021, 51, 151–161. [Google Scholar] [CrossRef]
- Al Shareef, H.F. Synthesis of some novel 2-(3-cyano -6-(thiophen- 2-yl)-4,4′- bipyridin-2- yloxy)acetohydrazide derivatives: Assessment of their cytotoxic activity. BMC Chem. 2020, 14, 40. [Google Scholar] [CrossRef] [PubMed]
- Boulguemh, I.E.; Beghidja, A.; Khattabi, L.; Long, J.; Beghidja, C. Monomeric and dimeric copper (II) complexes based on bidentate N′-(propan-2-ylidene) thiophene carbohydrazide Schiff base ligand: Synthesis, structure, magnetic properties, antioxidant and anti-Alzheimer activities. Inorganica Chim. Acta 2020, 507, 119519. [Google Scholar] [CrossRef]
- Shama, S.A.; El-Molla, M.M.; Basalah, R.F.; Saeed, S.E.S. Fading time study on prepared thymolphthalein, phenolphthalein and their mixture disappearing ink. Res. J. Text. Appar. 2008, 12, 9–18. [Google Scholar] [CrossRef]
- El-Molla, M.M.; Shama, S.A.; El-Sayed Saeed, S. Preparation of disappearing inks and studying the fading time on different paper surfaces. J. Forensic Sci. 2013, 58, 188–194. [Google Scholar] [CrossRef]
- Saeed, S.E.; Al-Harbi, T.M.; Alhakimi, A.N.; Abd El-Hady, M.M. Synthesis and Characterization of Metal Complexes Based on Aniline Derivative Schiff Base for Antimicrobial Applications and UV Protection of a Modified Cotton Fabric. Coatings 2022, 12, 1181. [Google Scholar] [CrossRef]
- Saeed, S.E.; Al-Harbi, T.M.; Abdel-Mottaleb, M.S.; Alhakimi, A.N.; Albadria, A.E.; Abd El-Hady, M.M. Novel Schiff base transition metal complexes for imparting UV protecting and antibacterial cellulose fabric: Experimental and computational investigations. Appl. Organomet. Chem. 2022, 36, e6889. [Google Scholar] [CrossRef]
- Saeed, S.E.; Alomari, B.A.; Abd El-Hady, M.M.; Alhakimi, A.N. Novel Pyrimidinethione Hydrazide Divalent and Trivalent Metal Complexes for Improved High-Performance Antimicrobial and Durable UV Blocking Cellulosic Fabric Inorganics. Inorganics 2023, 11, 231. [Google Scholar] [CrossRef]
- Saeed, S.E.; Aldubayyan, M.; Alhakimi, A.N.; El-Sayed, W.A.; Alnawmasi, J.S.; Abd El-Hady, M.M.; Abdel-Mottaleb, M.S. UV protective textile: Experimental and DFT computational studies on the function of some metal complexes of hydrazide derivatives on cellulose fabrics. Appl. Organomet. Chem. 2023, e7140. [Google Scholar] [CrossRef]
- Rostom, S.A.; Faidallah, H.M.; Al-Saadi, M.S. A facile synthesis of some 3-cyano-1,4,6-trisubstituted-2(1H)-pyridinones and their biological evaluation as anticancer agents. Med. Chem. Res. 2011, 8, 1260–1272. [Google Scholar] [CrossRef]
- ASTM D-1682-94. Standard Methods of Test for Breaking Load and Elongation of Textile Fabric. ASTM International: West Conshohocken, PA, USA, 1994.
- Bakhite, E.A.; Abdel-Rahman, A.E.; Mohamed, O.S.; Thabet, E.A. Synthesis and Reactions of Some New Heterocyclic Compounds Containing the Thienylthieno[2,3-b]pyridine Moiety. Phosphorus Sulfur Silicon Relat. Elem. 2004, 179, 1983–2006. [Google Scholar] [CrossRef]
- Kumar, N.S.; Krishnamurthy, G.; Pari, M.; Naik, T.R.; Kumara, K.J.; Naik, S.; Kandagalla, S.; Naik, N. Synthesis, characterization, electrochemistry, biological and molecular docking studies of the novel Co (II), Ni (II) and Cu (II) complexes derived from methanethiol bridged (2-((1H-benzo [d] imidazol-2-yl) methylthio)-1H-benzo [d] imidazol-6-yl)(phenyl) methanone. J. Mol. Struct. 2020, 1220, 128586. [Google Scholar]
- Alhakimi, A.N.; Shakdofa, M.M.; Saeed, S.E.; Shakdofa, A.M.; Al-Fakeh, M.S.; Abdu, A.; Alhagri, I. Transition Metal Complexes Derived from 2-hydroxy-4-(p-tolyldiazenyl)ben- zylidene)-2-(p-tolylamino)acetohydrazide Synthesis, Structural Characterization, and Biological Activities. J. Korean Chem. Soc. 2021, 65, 93–105. [Google Scholar]
- El-Shafiy, H.F.; Saif, M.; Mashaly, M.M.; Halim, S.A.; Eid, M.F.; Nabeel, A.I.; Fouad, R. New nano-complexes of Zn(II), Cu(II), Ni(II) and Co(II) ions; spectroscopy, thermal, structural analysis, DFT calculations and antimicrobial activity application. J. Mol. Struct. 2017, 1147, 452–461. [Google Scholar] [CrossRef]
- Rilda, Y.; Damara, D.; Putri, Y.E.; Refinel, R.; Agustien, A.; Pardi, H. Pseudomonas aeruginosa antibacterial textile cotton fiber construction based on ZnO–TiO2 nanorods template. Heliyon 2020, 6, e03710. [Google Scholar] [CrossRef]
- Balaban, A.; Çolak, N.; Ünver, H.; Erk, B.; Durlu, T.N.; Zengin, D.M. Synthesis, Spectroscopic Studies and Crystal Structure of N,N′-bis((thiophene-2-carboxamido)propyl)piperazine. J. Chem. Crystallogr. 2008, 38, 369–372. [Google Scholar] [CrossRef]
- Balaban, A.; Erk, B. Copper(II) and zinc(II) complexes of thiophene/furan carboxamides: Synthesis, structure and properties. Russ. J. Inorg. Chem. 2010, 55, 1094–1102. [Google Scholar]
- Balaban, G.A.; Özbek, N.; Karacan, N. Synthesis, characterization, and antibacterial activity of the ligands including thiophene/furan ring systems and their Cu (II), Zn (II) complexes. Med. Chem. Res. 2012, 21, 3435–3444. [Google Scholar] [CrossRef]
- Emam, S.M.; Tolan, D.A.; El-Nahas, A.M. Synthesis, structural, spectroscopic, and thermal studies of some transition-metal complexes of a ligand containing the amino mercapto triazole moiety. Appl. Organomet. Chem. 2020, 34, 591. [Google Scholar] [CrossRef]
- El-Boraey, H.A.; Emam, S.M.; Tolan, D.A.; El-Nahas, A.M. Structural studies and anticancer activity of a novel (N6O4) macrocyclic ligand and its Cu (II) complexes. Spectrochim. Acta A Mol. Biomol. Spectrosc. 2011, 78, 360–370. [Google Scholar] [CrossRef] [PubMed]
- Abd El-Hady, M.M. Preparation and characterization of chitosan/zinc oxide nanoparticles for imparting antimicrobial and UV protection to cotton fabric. Int. J. Carbohydr. Chem. 2012, 2012, 840591. [Google Scholar]
- Abd El-Hady, M.M.; Sharaf, S.; Farouk, A. Highly hydrophobic and UV protective properties of cotton fabric using layer by layer self-assembly technique. Cellulose 2019, 27, 1099–1110. [Google Scholar] [CrossRef]
- Singh, M.K.; Roy, S.; Hansda, A.; Kumar, S.; Kumar, M.; Kumar, V.; Peter, S.C.; John, R.P. Synthesis, characterization and antibacterial activity evaluation of trinuclear Ni (II) complexes with N-substituted salicylhydrazide ligands. Polyhedron 2017, 126, 100–110. [Google Scholar] [CrossRef]
- Mahmoud, W.H.; Mohamed, G.G.; El-Dessouky, M.M. Coordination modes of bidentate lornoxicam drug with some transition metal ions. Synthesis, characterization and in vitro antimicrobial and antibreastic cancer activity studies. Acta A Mol. Biomol. Spectrosc. 2014, 122, 598–608. [Google Scholar] [CrossRef]
- Saeed, S.E.; Alomari, B.A.; Alhakimi, A.N.; El-Hady, A.; Alnawmasi, J.S.; Elganzory, H.H.; El-Sayed, W.A. Pyrimidine hydrazide ligand and its metal complexes: Synthesis, characterization, and antimicrobial activities. Egypt. J. Chem. 2023, 66, 315–329. [Google Scholar] [CrossRef]

| Compound | ν (OH) | ν (CH2) | ν (C=O) | ν (C–O–C) | ν (C–O) | ν (M–O) | ν (M–N) | ν M–Cl |
| AHZ-CF | 3468–3191 br | 2896, 2850 m | 1652 m | 1160, 1106 m | 1053, 1028 s | - | - | - |
| Zn–AHZ-CF | 3466–3184 br | 2894, 2848 m | 1648 m | 1161, 1106 m | 1053, 1028 s | 591 w | 518 m | 434 m |
| Ni–AHZ-CF | 3467–3188 br | 2894, 2848 m | 1651 m | 1162, 1105 m | 1053, 1028 s | 590 w | 518 m | 434 w |
| Cu–AHZ-CF | 3464–3191 br | 2895, 2848 m | 1651 m | 1160, 1106 m | 1053, 1028 s | 592 w | 518 m | 435 w |
| Co–AHZ-CF | 3468–3189 br | 2895, 2848 m | 1648 m | 1160, 1105 m | 1053, 1028 s | 590 w | 518 m | 436 m |
| Cr–AHZ-CF | 3464–3183 br | 2895, 2846 m | 1650 m | 1161, 1105 m | 1053, 1028 s | 591 w | 518 m | 436 m |
| Mn–AHZ-CF | 3461–3183 br | 2896, 2851 m | 1651 m | 1160, 1106 m | 1053, 1028 s | 592 w | 518 m | 434 m |
| Fe–AHZ-CF | 3461–3187 br | 2896, 2851 m | 1650 m | 1160, 1106 m | 1053, 1028 s | 592 w | 518 m | 435 m |
| Fabric Coating | Inhibition Zone (mm/cm Sample) | Inhibition Zone (mm/cm Sample) | ||
|---|---|---|---|---|
| Gram (+ve) | Gram (−ve) | |||
| S. aureus | E. coli | C. albicans | A. flavus | |
| Blank | 0 | 0 | 0 | 0 |
| AHZ-CF | 11 | 10 | 0 | 0 |
| Zn−AHZ-CF | 18 | 18 | 19 | 0 |
| Ni−AHZ-CF | 21 | 18 | 11 | 0 |
| Cu−AHZ-CF | 16 | 15 | 14 | 0 |
| Co−AHZ-CF | 14 | 14 | 0 | 0 |
| Cr−AHZ-CF | 12 | 13 | 0 | 0 |
| Mn−AHZ-CF | 13 | 12 | 0 | 0 |
| Fe−AHZ-CF | 11 | 0 | 0 | 0 |
| Cotton Sample | Add-On (%) | Tensile Strength (Kg f) |
|---|---|---|
| Blank | - | 54.8 ± 0.2 |
| AHZ-CF | 2.17 ± 0.2 | 51.8 ± 0.2 |
| Zn−AHZ-CF | 4.5 ± 0.2 | 49.8 ± 0.2 |
| Ni−AHZ-CF | 5.97 ± 0.2 | 47.7 ± 0.3 |
| Cu−AHZ-CF | 5.75 ± 0.2 | 48.8 ± 0.2 |
| Co−AHZ-CF | 4.95 ± 0.2 | 48.50 ± 0.5 |
| Cr−AHZ-CF | 3.42 ± 0.2 | 50.67 ± 0.4 |
| Mn−AHZ-CF | 4.8 ± 0.2 | 49.32 ± 0.46 |
| Fe−AHZ-CF | 4.96 ± 0.2 | 48.3 ± 0.6 |
Disclaimer/Publisher’s Note: The statements, opinions and data contained in all publications are solely those of the individual author(s) and contributor(s) and not of MDPI and/or the editor(s). MDPI and/or the editor(s) disclaim responsibility for any injury to people or property resulting from any ideas, methods, instructions or products referred to in the content. |
© 2023 by the authors. Licensee MDPI, Basel, Switzerland. This article is an open access article distributed under the terms and conditions of the Creative Commons Attribution (CC BY) license (https://creativecommons.org/licenses/by/4.0/).
Share and Cite
Saeed, S.E.-S.; Aldubayyan, M.; Al-Hakimi, A.N.; El-Hady, M.M.A. Synthesis and Characterization of Pyridine Acetohydrazide Derivative for Antimicrobial Cotton Fabric. Materials 2023, 16, 4885. https://doi.org/10.3390/ma16134885
Saeed SE-S, Aldubayyan M, Al-Hakimi AN, El-Hady MMA. Synthesis and Characterization of Pyridine Acetohydrazide Derivative for Antimicrobial Cotton Fabric. Materials. 2023; 16(13):4885. https://doi.org/10.3390/ma16134885
Chicago/Turabian StyleSaeed, Saeed El-Sayed, Meaad Aldubayyan, Ahmed N. Al-Hakimi, and Marwa M. Abd El-Hady. 2023. "Synthesis and Characterization of Pyridine Acetohydrazide Derivative for Antimicrobial Cotton Fabric" Materials 16, no. 13: 4885. https://doi.org/10.3390/ma16134885
APA StyleSaeed, S. E.-S., Aldubayyan, M., Al-Hakimi, A. N., & El-Hady, M. M. A. (2023). Synthesis and Characterization of Pyridine Acetohydrazide Derivative for Antimicrobial Cotton Fabric. Materials, 16(13), 4885. https://doi.org/10.3390/ma16134885

